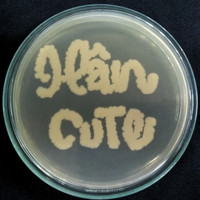

Xác thực mật khẩu
Thanh toán thẻ tín dụng
Foody Corporation sử dụng cổng thanh toán CyberSource - Visa Company để tích hợp vào hệ thống. Thẻ của quý khách được kiểm tra và thực hiện giao dịch từ CyberSource, Foody không biết được thông tin thẻ của quý khách và không lưu trữ trên hệ thống cơ sở dữ liệu của Foody. Phương thức giao dịch được bảo đảm an toàn với sự hợp tác của ngân hàng Sacombank & Foody Corporation.
Foody sẽ thực hiện giao dịch sau khi nhân viên giao đơn hàng đến tận tay quý khách. Nếu xảy ra nhầm lẫn hoặc giao dịch sai lệch, nhân viên Foody sẽ liên hệ quý khách để xử lý, hoặc quý khách có thể gửi yêu cầu đến email info@foody.vn để được hỗ trợ.
-
Chọn bộ sưu tập để lưu lại

-
-
Chọn bộ sưu tập để lưu lại

Tìm địa điểm trên đường đi? Tải app Foody!
Thống kê
334,384 Địa điểm
toàn quốc
38,630,265 người sử dụng
trong & ngoài nước
1,481,841 bình luận
đã chia sẻ
608,066 check-in
đã thực hiện
10,232,333 hình ảnh
được tải lên
24,623,376 Bộ sưu tập
bộ sưu tập được tạo